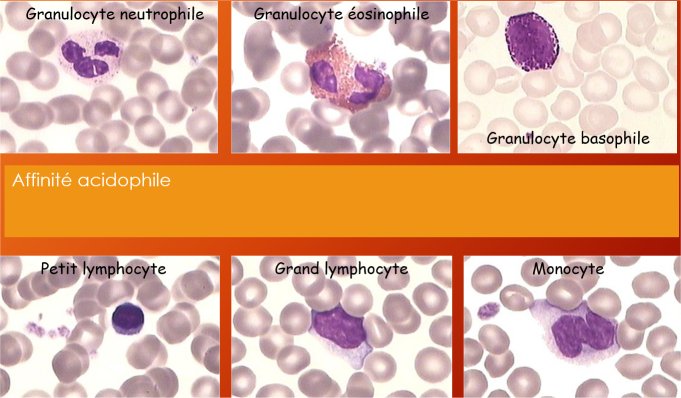

espace pédagogique > disciplines du second degré > biotechnologies-santé-social > ressources pédagogiques
frottis sanguin et coloration au MGG
mis à jour le 30/11/2015
diaporama présentant les aspects théorique et pratique de la réalisation des frottis sanguins et de leur coloration au May Grünwald Giemsa
mots clés : hématologie, étalement, coloration, frottis, BTS ABM, STL
Logo et photos du diaporama
Crédits : Catherine POCHET
Ce diaporama peut être utilisé en préliminaire ou lors d'une séance de travaux pratiques
Il peut être facilement séparé en trois parties selon l'avancement des manipulations.
 |
|
| 2. Les suivantes exposent la technique de coloration classique au May Grünwald Giemsa. |  |
| 3. Enfin viennent des explications sur le principe de la coloration, comment les ions colorants se fixent sur les structures cellulaires et leur donnent des colorations spécifiques de leur affinité. Les quatre affinités sont illustrées d'exemples complets. |
Equipe pédagogique (Jean MOULIN ANGERS)
information(s) pédagogique(s)
niveau : bts, Terminale STL, dut
type pédagogique : travaux pratiques, leçon
public visé : élève, étudiant
contexte d'usage : laboratoire, classe
référence aux programmes : Classe de Terminale STL BGB
Classe de Section de BTS ABM, BioAC, DUT, DETAB
fichier joint
information(s) technique(s) : présentation .pptx accessible grâce au logiciel PowerPoint de Microsoft Office ou au logiciel gratuit de la série Open Office
taille : 397 Ko ;
biotechnologies-santé-social - Rectorat de l'Académie de Nantes

 s'identifier
s'identifier
 portail personnel ETNA
portail personnel ETNA
